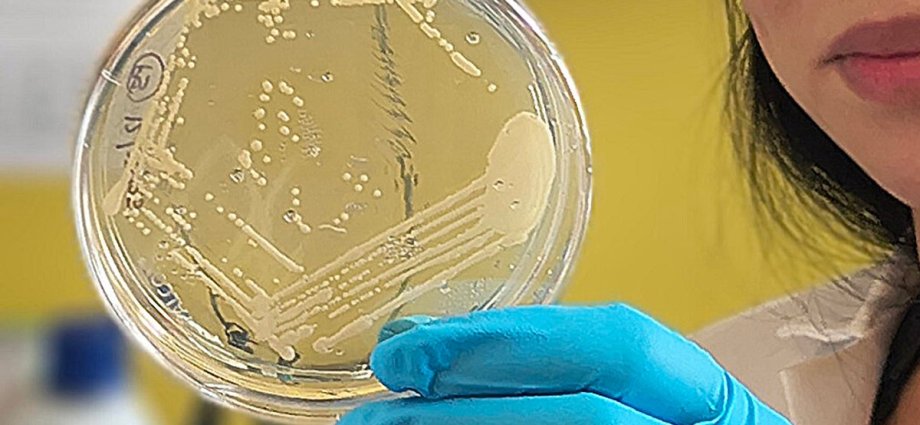

A new study could help demystify a rare gastrointestinal condition that causes patients’ own bodies to produce alcohol, making them experience intoxication without drinking.
Known as auto-brewery syndrome or ABS, the extremely rare condition often goes undiagnosed due to a lack of awareness, diagnostic challenges, and stigma.
Researchers have now identified specific gut bacteria that appear to be driving alcohol production in patients with the condition, and say their work could lead to new methods for treating the disease.
In some cases, the level of alcohol produced from the gut can be high enough to cause noticeable intoxication and gradually induce liver damage, cognitive impairment, digestive issues, and withdrawal symptoms.
Patients may experience years of misdiagnosis and social, medical and legal consequences before receiving a proper diagnosis.
However, very little is known about the specific gut bacteria that cause ABS.
In the largest study of the condition to date, scientists assessed 22 ABS patients and compared their health profiles with those of 21 unaffected household partners.
Researchers found that stool samples taken from patients during an ABS flare yielded significantly more ethanol than those from their healthy household partners.
“We found that gut bacteria, including Escherichia coli and Klebsiella pneumoniae, ferment sugars into ethanol in the intestine in patients with ABS,” Bernd Schnabl, a professor of medicine from the University of California San Diego School of Medicine, said.
“These microbes use several ethanol-producing pathways and drive blood-alcohol levels high enough to cause legal intoxication,” said Dr Schnabl, author of the study published in the journal Nature Microbiology.

While some patients carried these organisms, researchers said the exact microbes responsible for ABS in individual patients could vary.
Some patients also had much higher levels of microbial enzymes involved in fermentation during ABS flares compared with controls, the research found.
“Faecal samples from individuals with ABS during a flare produced more ethanol in vitro, which could be reduced by antibiotic treatment,” scientists wrote in the study.
Researchers theorise that treatments targeting these enzymes may be a more effective strategy.
“These findings can inform future clinical interventions for ABS,” they wrote.
A stool-based test could also be a better alternative to the currently used diagnosis method of blood alcohol testing, they said.
One patient appeared to experience symptom relief after undergoing a faecal microbiota transplantation, according to the study.
This patient was symptom-free for more than 16 months after a second faecal microbiota transplant.
“Our study demonstrates the potential for fecal transplantation,” Elizabeth Hohmann, another study author from Mass General Brigham Department of Medicine, said.
“By determining the specific bacteria and microbial pathways responsible, our findings may lead the way toward easier diagnosis, better treatments, and an improved quality of life for individuals living with this rare condition.”